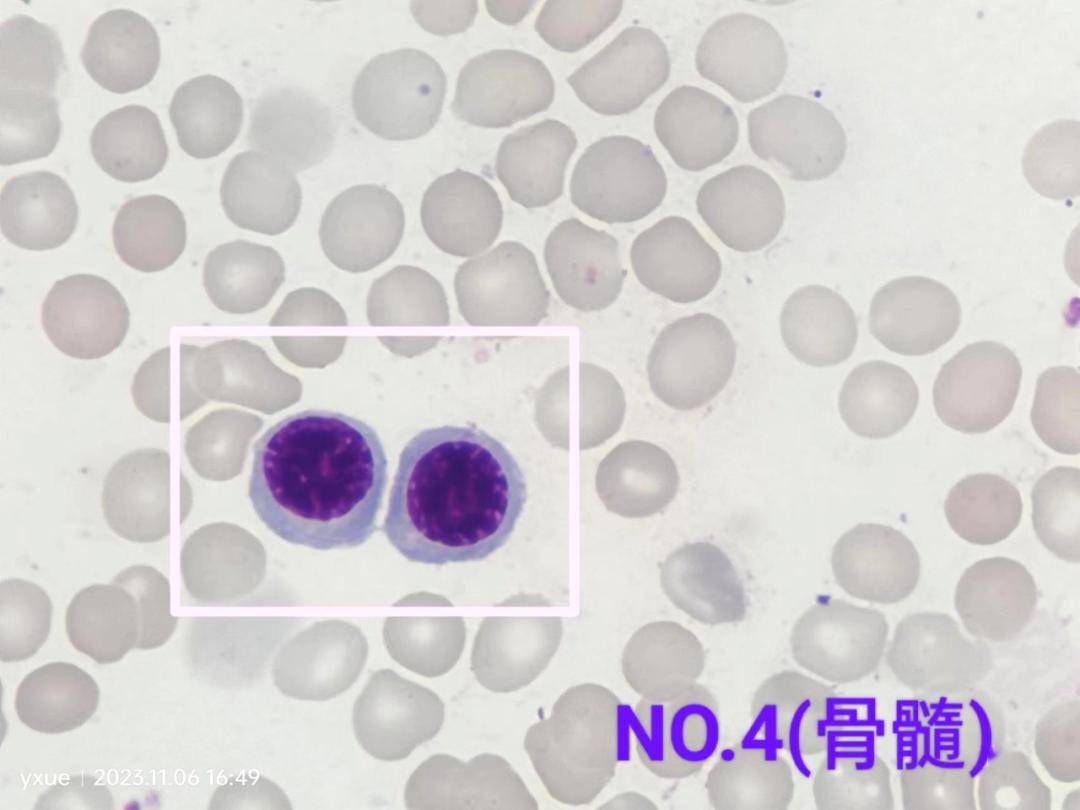
看图识细胞(第126期)

细胞识别

细胞间识别
图片尺寸259x300
看图识细胞之五种类别白细胞!#生命科学 #医学科普 #显微 - 抖音
图片尺寸1158x1952
血液学检验 骨髓片 细胞鉴定表 - 抖音
图片尺寸1080x608
细胞识别
图片尺寸600x343
【学点免疫分型】之细胞识别
图片尺寸559x654
基于yolov5的血细胞识别和计数
图片尺寸858x642
看图识细胞11
图片尺寸1080x1439
植物学——植物细胞.#dou是知识点 #每天持续分享科普知识 - 抖音
图片尺寸428x512
一起学习认识显微镜下细胞!#血色浪漫 #血液细胞图 #细胞 - 抖音
图片尺寸1080x1328
高一生物下期--第一讲:走进细胞.接上期分享!新来的小伙伴可 - 抖音
图片尺寸1242x1660
张时民日常检验工作经验谈如何识别复粒细胞
图片尺寸902x623
骨髓细胞和外周血细胞的识别(24个兄弟姐妹),诊断标本考试_哔哩哔哩
图片尺寸1700x2200
看图认细胞.#医学科普 #医学检验 #每天学习一点点 #血细 - 抖音
图片尺寸946x632
细胞增殖检测99.
图片尺寸1438x1856
细胞的多样性与统一性课件 高一上学期生物人教版必修1_第3页
图片尺寸1500x1125
高中生物特殊的41种细胞,不知道的小伙伴快快收藏吧#关注我每 - 抖音
图片尺寸1224x1734
看图识细胞(第126期)
图片尺寸1080x810
宠物血液学检验犬猫兔白细胞的识别图谱
图片尺寸640x467
高中生物 一轮复习 走近细胞3(原核细胞和真核细胞)***重点!
图片尺寸1440x1080
检验人爱的干货!血细胞典型形态学图谱(118张)
图片尺寸1080x810